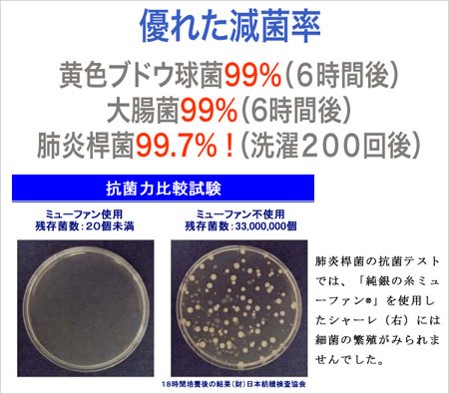

足部净化器~肉眼可見的殺菌銀纖維
Apr 26. 2021
銀纖維的作用
鍍純的銀纖維有很好的抑制細菌功能,這是因爲在溫暖潮濕的環境裏,銀有非常高的生物活性,極易與其他物質結合。此時,纖維上銀離子通過將細菌細胞膜內外的蛋白質凝固,殺死或抑制細菌的繁殖,防止有機物腐敗分散而産生的臭氣,達到除臭目的。
美國賓西法尼亞大學,1987年就開始測試幷取得了許多研究成果,銀纖維一小時內抑制 99.9% 暴露于織物表面的細菌,非常迅速的將金黃色葡萄球菌、大腸杆菌、沙門氏菌、白癬菌、支原體、衣原體等細菌殺死, 最多可殺死 650 多種細菌。
肉眼可見"銀"的三明治製程
美信機能實驗室整合了日本百年大廠豐島的鍍銀纖維, 將鍍銀纖維以三明治的方式包裹起來, 在透明的聚酯薄膜(厚度為9μm)上作純銀鍍膜(厚度約0.1μm),鍍膜上再覆蓋一層同厚度的9μm的聚酯膜,然後將其切成230μm或150μm寬的細條絲。

這種採用「銀片」製成的紡織用銀纖維,既具有原絲的柔軟耐拉功能,又具有抗菌、防臭、吸脚汗的功效,是一種自然界天然元素同現代科技的有效結合。
整個脚趾被銀纖維完全包覆

發光的銀纖維
既然是銀,就應該應該會有反應,我們實際用金屬探測筆實際測試一下,還真的能發光哦!!!

脚掌各個部位都測一下,還真的都發亮了~~~

360度環繞的銀纖維
銀除了除了前脚掌,在整個脚背和足底,也都有銀纖維360°環繞,抑菌能力應該沒話說

Air Pump 足跟緩衝設計
在足底設計了緩衝區,最適合需要穿皮鞋的上班族了

杜邦耐磨的帳棚紗足底
這樣應該能避免露出大腳趾的尷尬了....

萊卡彈力鬆緊帶
穿久了也不擔心滑落.

規格一覽表

